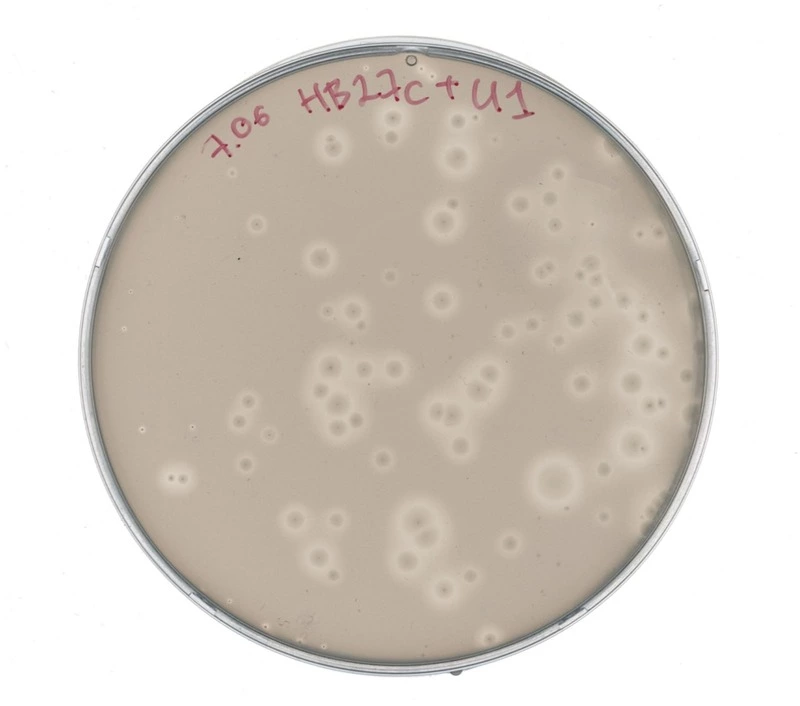

Как рассказали в заповеднике «Курильский», трое аспирантов — Карина Корнеева, Матвей Колесник и Константин Гилеп в течение недели отбирали пробы воды и почвы. Всего они собрали порядка шести образцов почв различных биотопов и около 30 образцов воды. Известно, что образцы воды ученые взяли из горячих источников на мысе Горячий, в районе поселка Третьяково, на Столбовских источниках, на ручье Кислый, на Северо-Западном сольфатарном поле вулкана Менделеева и на трех сольфатарных полях вокруг озера Горячее в кальдере вулкана Головнина. Это объясняется тем, что специалистов интересовали кислые и нейтральные по уровню pH источники, где температура воды выше 60 градусов.
Так, из кислых источников исследователи пытались выделить гипертермоацидофильных архей, а из нейтральных источников — определенные гипертермофильные бактерии. Еще одной задачей ученых стал поиск вирусов, которые заражают бактериальные клетки (бактериофагов) и вирусов, заражающих археи.
Модельными организмами по «выращиванию» бактериофагов исследователи выбрали термофильные бактерии Thermus thermophilus, для поиска вирусов архей — археи рода Sulfolobus. Так, первые результат исследований ученые получили в кальдере вулкана Головнина. Они взяли с собой культуры бактерий T. thermophilus, добавили к ним пробы воды и оставили инкубироваться, при этом используя горячий песок на берегу озера Кипящее как термостат. Позже в нескольких пробирках увеличилось число бактерий, а в некоторых пробирках предположительно пошел процесс лизиса - разрушения клеток под действием бактериофагов. Еще в четырех образцах воды исследователи обнаружили бактериальные вирусы.
Кроме того, во время поисков бактериофагов ученые обнаружили еще одно необычное явление — в пробах воды содержались термофильные бактерии, которые производили антибактериальные вещества. По словам исследователей, на одной чашке в слое мягкого агара, в которой была вода из горячего источника, выросли колонии новых бактерий.
«Выглядит так, будто эти неизвестные бактерии выделяют в среду какие-то антибиотики, убивающие клетки T. thermophilus. Среди бацилл есть довольно много термофильных организмов, и некоторые из них действительно выделяют антибиотики. Возможно, на нашей чашке вырос как раз кто-то из подобных организмов. Выглядит очень интересно, будем разбираться дальше» — написали ученые в своем Telegram-канале.

На сегодняшний день все внимание исследователей обращено на новые методы борьбы с бактериями, которые являются патогенными для человеческого организма. Матвей Колесник пояснил, что часть их исследований микроорганизмов направлена на поиск новых белков с интересными свойствами.
«Такие белки при помощи специальной «направляющей молекулы» можно «запрограммировать» на узнавание и расщепление определенной последовательности ДНК, и при помощи таких инструментов можно, к примеру, заменить в геноме «сломанный» ген на «рабочий», — рассказал Матвей Колесник в своем Telegram-канале.
Ранее сотрудники заповедника «Курильский» и добровольцы провели экоакцию на Кунашире. Чистые воды рек и ручьев помогают процветать большому количеству рыб, которые являются питанием для множества птиц и наземных хищников.
РИА «Сахалин-Курилы».